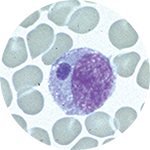

Ehrlichiosis is the general name used to describe diseases caused by the bacteria Ehrlichia chaffeensis, E. ewingii, or E. muris eauclairensis in the United States. The majority of reported cases are due to infection by E. chaffeensis.
Ehrlichia chaffeensis in a white blood cell. Photo: Centers for Disease Control and Prevention.
- Transmission
E. chaffeensis and E. ewingii are transmitted in Indiana by the bite of infected lone star ticks (Amblyomma americanum). The bacteria E. muris eauclairensis is transmitted by the bite of infected blacklegged ticks (Ixodes scapularis). Human infections with E. muris eauclairensis have only been found in Wisconsin and Minnesota. Rarely, Ehrlichia species have been spread through blood transfusions and organ transplants.
- Signs and Symptoms
Signs and symptoms of ehrlichiosis usually appear within 1–2 weeks after the bite of an infected tick. People in the early stages of illness can experience flu-like symptoms, such as:
- Fever and chills
- Severe headache
- Muscle aches
- Nausea, vomiting, diarrhea, or loss of appetite
- Confusion
- Rash (more common in children)
Untreated ehrlichiosis can rapidly progress to a serious and life-threatening illness. Older people and those with weakened immune systems are more likely to develop serious illness.
- Diagnosis
Diagnosis of ehrlichiosis is based upon the patient’s signs and symptoms, a history of possible exposure to ticks, and appropriate laboratory testing. Early recognition of symptoms is important for prompt diagnosis and treatment. If you think you have ehrlichiosis, contact your healthcare provider right away.
People who have removed an attached tick sometimes wonder if they should have it tested for tick-borne diseases. Although some laboratories offer this testing, IDOH does not recommend it. If the tick tests positive, it does not necessarily mean that you have been infected; if the tick tests negative, it may provide a false sense of security because you may have been unknowingly bitten by a different tick that was infected.
- Treatment
Doxycycline is the treatment of choice for adults and children of all ages with suspected ehrlichiosis. Doxycycline is most effective at preventing severe complications and death if it is started early in the course of illness. Treatment should be started for anyone with suspected ehrlichiosis and should never be delayed while waiting for laboratory results.
- Prevention
The best way to prevent ehrlichiosis is to avoid tick bites. Please see our tick prevention page for more information.
For more information about ehrlichiosis, please visit the CDC ehrlichiosis webpage.
- Maps and Statistics
For ehrlichiosis maps and statistics in Indiana, please visit the Indiana Tick-borne Disease Surveillance dashboard.
National statistics for ehrlichiosis can be found at the CDC Epidemiology and Statistics webpage.
- Resources
Information for Providers
For ehrlichiosis diagnosis, treatment, and testing information, click here.

